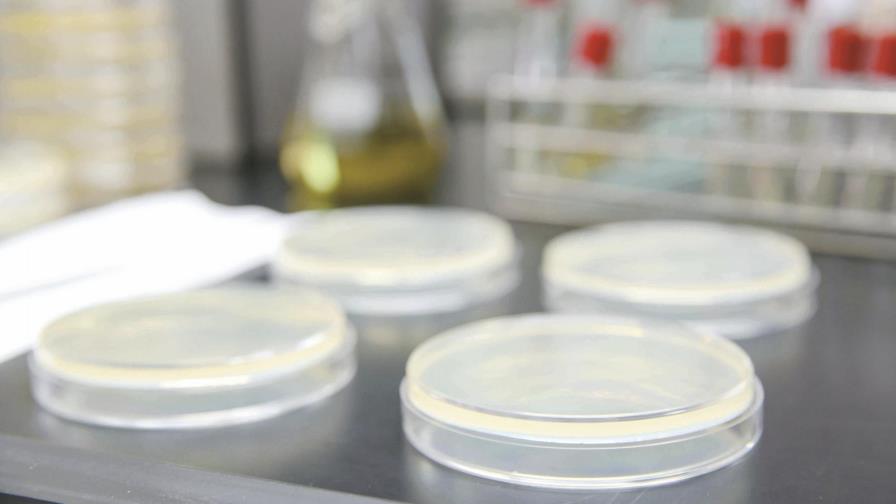
En 2017 han aumentado 10% los casos de tuberculosis en Nueva York

En 2017 han aumentado 10% los casos de tuberculosis en Nueva York
Hay afectados de China, India República Dominicana y Ecuador,
NUEVA YORK. Los casos de tuberculosis experimentaron un alza del diez por ciento en Nueva York en 2017, el incremento más grande reportado en la ciudad en veinticinco años, de acuerdo con un informe publicado ayer por el Departamento de Salud.
El documento indica que el año pasado se confirmaron 613 nuevos casos, un diez por ciento más que los 556 del año anterior.
El 41 % de ellos afectó a gente entre los 18 y 44 años de edad, mientras que, en cuanto a raza, los negros no hispanos componen el 43 % de los casos diagnosticados entre los pacientes nacidos en EE.UU.
El informe, que se publica en el Día Mundial de la Tuberculosis, muestra que los casos se registraron en casi todos los distritos de la ciudad, en pacientes de diversos países, incluido de EE.UU.
Según el comunicado de prensa de la agencia sanitaria, aumentaron a catorce los pacientes resistentes a los dos antibióticos más importantes para tratar la enfermedad. Uno de ellos es extremadamente resistente al tratamiento, lo que lo hace más difícil y costoso, agrega el comunicado, y cinco son resistentes a uno de los medicamentos.
La agencia destacó además que la enfermedad continúa afectando de forma desproporcionada a emigrantes, que componen el 86 por ciento de los pacientes, que provienen en su mayoría de China, la República Dominicana, Ecuador, India y México.
Dentro de Nueva York, Queens continúa siendo el distrito con la mayor tasa de casos, de 10,6 por 100.000 habitantes, en contraste con la tasa de 7,5 para toda la ciudad.
“La tuberculosis es una enfermedad mortal, pero curable”, dijo la directora de Salud, Mary T. Bassett, quien manifestó su preocupación por el incremento del último año. Bassett recordó que la agencia que dirige ofrece servicios gratis en diversas clínicas de la ciudad para tratar la enfermedad. EFE

 EFE
EFE
 EFE
EFE